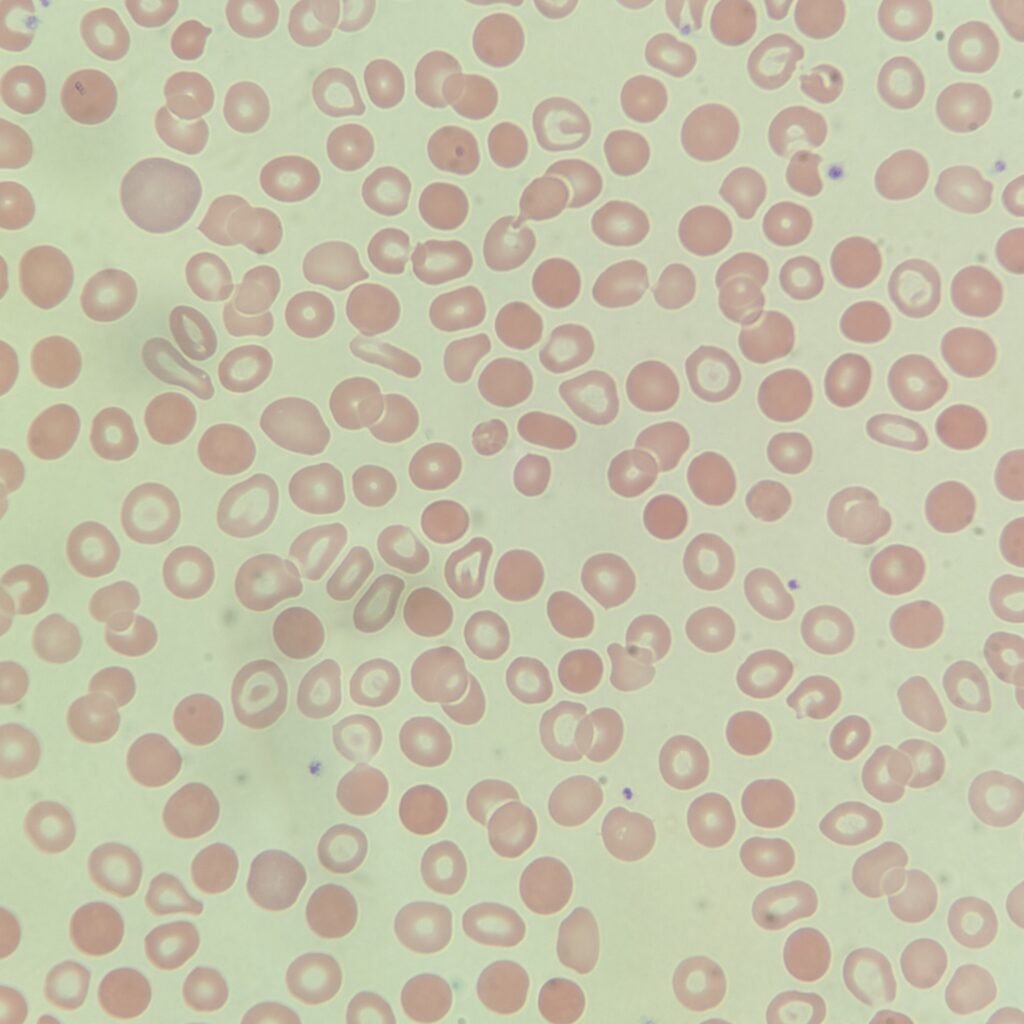
Spherocytes, red blood cell morphology
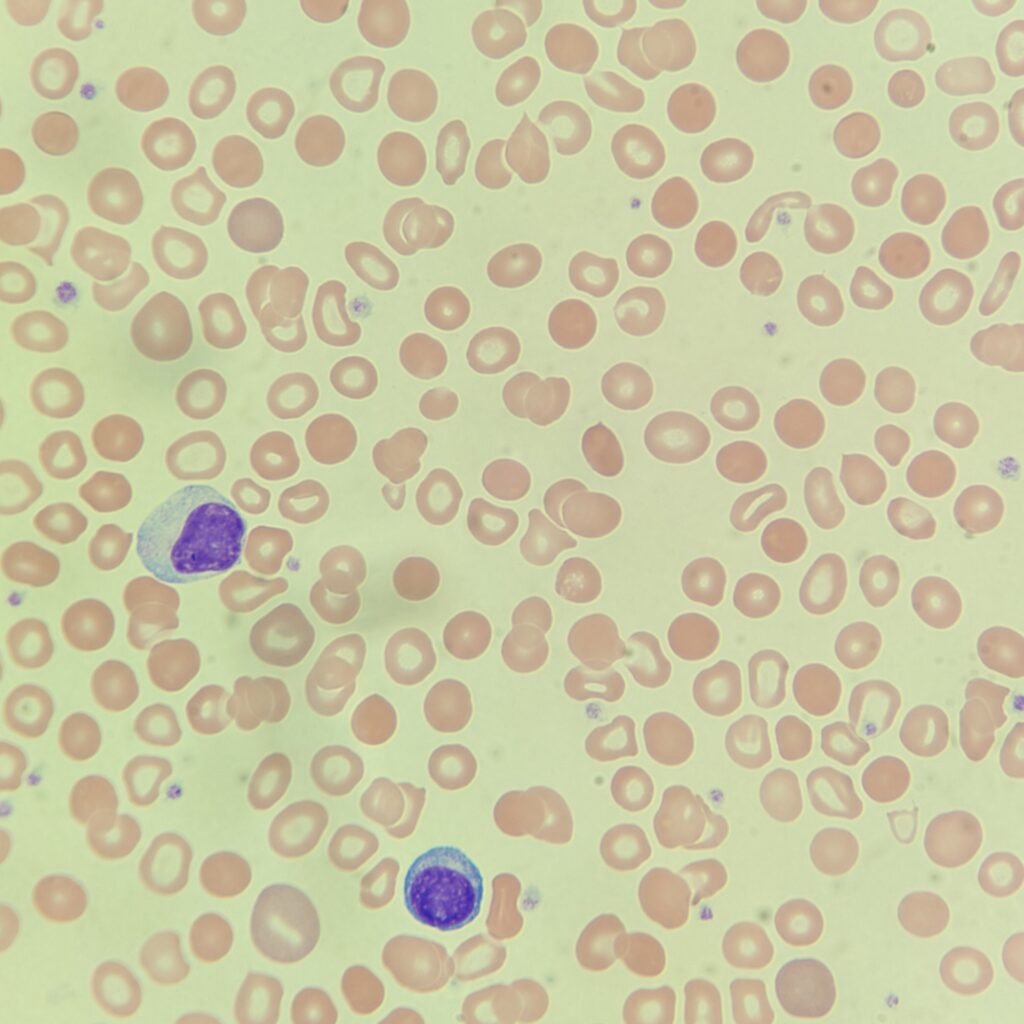
Spherocytes, red blood cell morphology

Spherocytes form as a result of extravascular hemolysis. Macrophages remove part of the red blood cell, decreasing its volume. The remaining hemoglobin is now concentrated to a smaller area which is why spherocytes stain more densely. Mean Cell Hemoglobin Concentration (MCHC) will be increased in spherocytes. These cells are seen in immune hemolytic anemia, post-transfusion, and severe burns. Alternatively, spherocytosis may be hereditary. In this case, a fault in the vertical proteins that hold the membrane together cause the red blood cell to lose its biconcave shape. These cells have increased osmotic fragility.
They may also appear as artifacts in thinner areas of the slide where red blood cells have a cobblestone effect.
Appearance
Spherocytes are small, spherical red blood cells that stain densely and lack central pallor.

Gallery